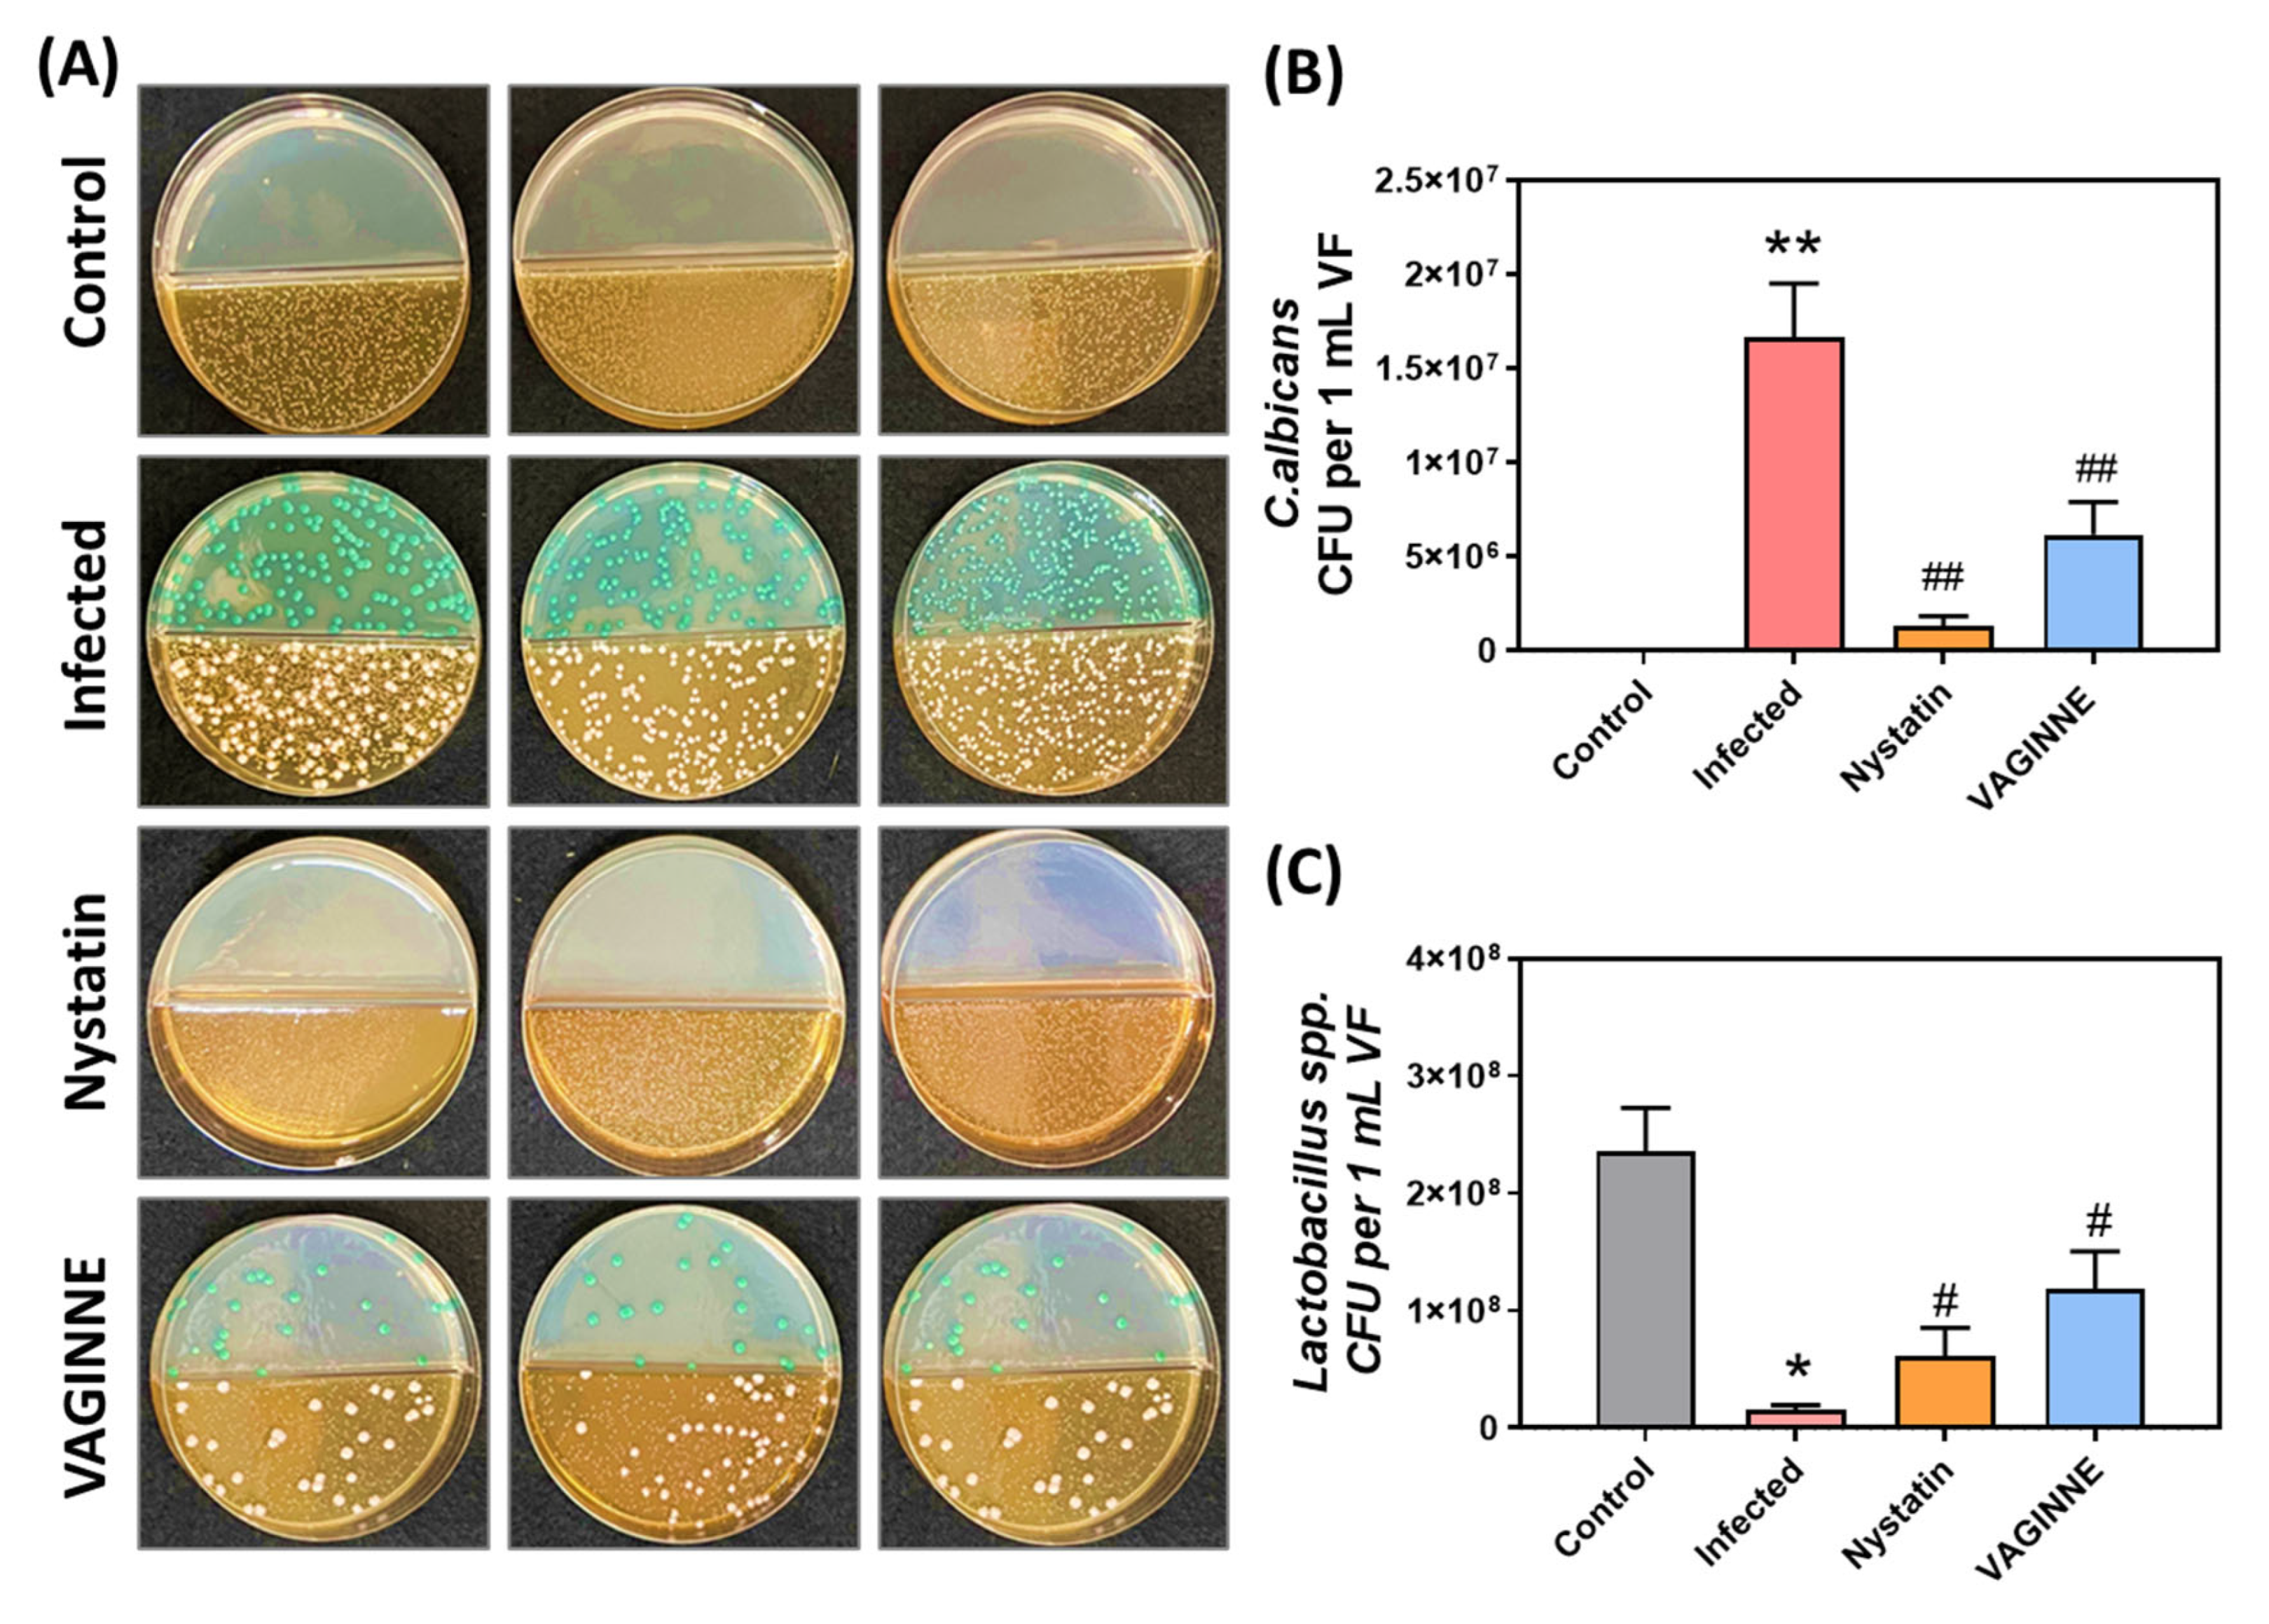
Jof 11 00018 g003

Dual Mechanisms of Action: Anti-Candida and Anti-Inflammatory Potential of Lactobacillus Fermentation Broth in Treating Vulvovaginal Candidiasis
Abstract
1. Introduction
2. Materials and Methods
2.1. Animal Model
2.2. Preparation of VAGINNE®
2.3. Animal Model and Treatment Protocol
- Control: Uninfected, received carbomer gel;
- Infected: Received C. albicans and carbomer gel;
- Nystatin: Received C. albicans and 2.6% nystatin gel (positive control);
- VAGINNE®: Received C. albicans and VAGINNE® gel.
2.4. Colony Counts of C. albicans and Lactobacillus spp.
2.5. Tissue Histopathology
2.6. Enzyme-Linked Immunosorbent Assay (ELISA)
2.7. Statistical Analysis
3. Results
3.1. Effect of Fermentation Broth on Vaginal Discharge and Inflammation in C. albicans-Infected Mice
3.2. Impact of Fermentation Broth on C. albicans and Lactobacillus spp. Colony Counts in Vaginally Infected Mice
3.3. Histological Analysis of Vaginal Tissue Following Fermentation Broth Treatment in Infected Mice
3.4. Influence of Fermentation Broth on Hematological Indexes in C. albicans-Infected Mice
3.5. Fermentation Broth Effects on Proinflammatory Cytokines in Infected Mice
4. Discussion
5. Conclusions
Supplementary Materials
Author Contributions
Funding
Institutional Review Board Statement
Data Availability Statement
Acknowledgments
Conflicts of Interest
References
- Sobel, J.D.; Faro, S.; Force, R.W.; Foxman, B.; Ledger, W.J.; Nyirjesy, P.R.; Reed, B.D.; Summers, P.R. Vulvovaginal candidiasis: Epidemiologic, diagnostic, and therapeutic considerations. Am. J. Obs. Gynecol. 1998, 178, 203–211. [Google Scholar] [CrossRef] [PubMed]
- Sobel, J.D. Pathogenesis and treatment of recurrent vulvovaginal candidiasis. Clin. Infect. Dis. 1992, 14 (Suppl. 1), S148–S153. [Google Scholar] [CrossRef] [PubMed]
- Gaziano, R.; Sabbatini, S.; Monari, C. The Interplay between Candida albicans, Vaginal Mucosa, Host Immunity and Resident Microbiota in Health and Disease: An Overview and Future Perspectives. Microorganisms 2023, 11, 1211. [Google Scholar] [CrossRef] [PubMed]
- Zangl, I.; Pap, I.J.; Aspock, C.; Schuller, C. The role of Lactobacillus species in the control of Candida via biotrophic interactions. Microb. Cell 2019, 7, 1–14. [Google Scholar] [CrossRef]
- Ardizzoni, A.; Wheeler, R.T.; Pericolini, E. It Takes Two to Tango: How a Dysregulation of the Innate Immunity, Coupled with Candida Virulence, Triggers VVC Onset. Front. Microbiol. 2021, 12, 692491. [Google Scholar] [CrossRef]
- Spampinato, C.; Leonardi, D. Candida infections, causes, targets, and resistance mechanisms: Traditional and alternative antifungal agents. Biomed. Res. Int. 2013, 2013, 204237. [Google Scholar] [CrossRef]
- Sheehan, D.J.; Hitchcock, C.A.; Sibley, C.M. Current and emerging azole antifungal agents. Clin. Microbiol. Rev. 1999, 12, 40–79. [Google Scholar] [CrossRef]
- Hof, H. A new, broad-spectrum azole antifungal: Posaconazole—Mechanisms of action and resistance, spectrum of activity. Mycoses 2006, 49 (Suppl. 1), 2–6. [Google Scholar] [CrossRef]
- Sullivan, D.J.; Moran, G.P.; Pinjon, E.; Al-Mosaid, A.; Stokes, C.; Vaughan, C.; Coleman, D.C. Comparison of the epidemiology, drug resistance mechanisms, and virulence of Candida dubliniensis and Candida albicans. FEMS Yeast Res. 2004, 4, 369–376. [Google Scholar] [CrossRef]
- Peters, B.M.; Yano, J.; Noverr, M.C.; Fidel, P.L., Jr. Candida vaginitis: When opportunism knocks, the host responds. PLoS Pathog. 2014, 10, e1003965. [Google Scholar] [CrossRef]
- Mulu, A.; Kassu, A.; Anagaw, B.; Moges, B.; Gelaw, A.; Alemayehu, M.; Belyhun, Y.; Biadglegne, F.; Hurissa, Z.; Moges, F.; et al. Frequent detection of ‘azole’ resistant Candida species among late presenting AIDS patients in northwest Ethiopia. BMC Infect. Dis. 2013, 13, 82. [Google Scholar] [CrossRef] [PubMed]
- Pasqualotto, A.C.; Rosa, D.D.; Medeiros, L.R.; Severo, L.C. Candidaemia and cancer: Patients are not all the same. BMC Infect. Dis. 2006, 6, 50. [Google Scholar] [CrossRef] [PubMed]
- Krcmery, V.; Barnes, A.J. Non-albicans Candida spp. causing fungaemia: Pathogenicity and antifungal resistance. J. Hosp. Infect. 2002, 50, 243–260. [Google Scholar] [CrossRef] [PubMed]
- Nunn, K.L.; Forney, L.J. Unraveling the Dynamics of the Human Vaginal Microbiome. Yale J. Biol. Med. 2016, 89, 331–337. [Google Scholar] [PubMed]
- Lamont, R.F.; Sobel, J.D.; Akins, R.A.; Hassan, S.S.; Chaiworapongsa, T.; Kusanovic, J.P.; Romero, R. The vaginal microbiome: New information about genital tract flora using molecular based techniques. BJOG 2011, 118, 533–549. [Google Scholar] [CrossRef]
- MacAlpine, J.; Daniel-Ivad, M.; Liu, Z.; Yano, J.; Revie, N.M.; Todd, R.T.; Stogios, P.J.; Sanchez, H.; O’Meara, T.R.; Tompkins, T.A.; et al. A small molecule produced by Lactobacillus species blocks Candida albicans filamentation by inhibiting a DYRK1-family kinase. Nat. Commun. 2021, 12, 6151. [Google Scholar] [CrossRef]
- Wang, S.; Wang, Q.; Yang, E.; Yan, L.; Li, T.; Zhuang, H. Antimicrobial Compounds Produced by Vaginal Lactobacillus Crispatus Are Able to Strongly Inhibit Candida Albicans Growth, Hyphal Formation and Regulate Virulence-Related Gene Expressions. Front. Microbiol. 2017, 8, 564. [Google Scholar] [CrossRef]
- Luan, C.; Jiang, N.; Zhou, X.; Zhang, C.; Zhao, Y.; Li, Z.; Li, C. Antibacterial and anti-biofilm activities of probiotic Lactobacillus curvatus BSF206 and Pediococcus pentosaceus AC1-2 against Streptococcus mutans. Microb. Pathog. 2022, 164, 105446. [Google Scholar] [CrossRef]
- Chetwin, E.; Manhanzva, M.T.; Abrahams, A.G.; Froissart, R.; Gamieldien, H.; Jaspan, H.; Jaumdally, S.Z.; Barnabas, S.L.; Dabee, S.; Happel, A.U.; et al. Antimicrobial and inflammatory properties of South African clinical Lactobacillus isolates and vaginal probiotics. Sci. Rep. 2019, 9, 1917. [Google Scholar] [CrossRef]
- Chaillou, S.; Champomier-Verges, M.C.; Cornet, M.; Crutz-Le Coq, A.M.; Dudez, A.M.; Martin, V.; Beaufils, S.; Darbon-Rongere, E.; Bossy, R.; Loux, V.; et al. The complete genome sequence of the meat-borne lactic acid bacterium Lactobacillus sakei 23K. Nat. Biotechnol. 2005, 23, 1527–1533. [Google Scholar] [CrossRef]
- Conti, H.R.; Gaffen, S.L. Host responses to Candida albicans: Th17 cells and mucosal candidiasis. Microbes Infect. 2010, 12, 518–527. [Google Scholar] [CrossRef] [PubMed]
- Korn, T.; Bettelli, E.; Oukka, M.; Kuchroo, V.K. IL-17 and Th17 Cells. Annu. Rev. Immunol. 2009, 27, 485–517. [Google Scholar] [CrossRef] [PubMed]
- Sun, X.; Gao, Y.; Ding, Z.; Zhao, Y.; Yang, Y.; Sun, Q.; Yang, X.; Ge, W.; Xu, X.; Cheng, R.; et al. Soluble beta-glucan salecan improves vaginal infection of Candida albicans in mice. Int. J. Biol. Macromol. 2020, 148, 1053–1060. [Google Scholar] [CrossRef] [PubMed]
- Guo, X.; Jing, T.; Li, X.; Liu, Z.; Chen, Y.; Li, Y.; Xu, Y.; Gao, H. Effects of Boric Acid Gel on Vaginal Candida albicans Infections and the Local Immune System in Mice. Front. Immunol. 2022, 13, 950215. [Google Scholar] [CrossRef]
- Shackelford, C.; Long, G.; Wolf, J.; Okerberg, C.; Herbert, R. Qualitative and quantitative analysis of nonneoplastic lesions in toxicology studies. Toxicol. Pathol. 2002, 30, 93–96. [Google Scholar] [CrossRef]
- Munyaka, P.M.; Rabbi, M.F.; Khafipour, E.; Ghia, J.E. Acute dextran sulfate sodium (DSS)-induced colitis promotes gut microbial dysbiosis in mice. J. Basic Microbiol. 2016, 56, 986–998. [Google Scholar] [CrossRef]
- George, F.; Daniel, C.; Thomas, M.; Singer, E.; Guilbaud, A.; Tessier, F.J.; Revol-Junelles, A.M.; Borges, F.; Foligne, B. Occurrence and Dynamism of Lactic Acid Bacteria in Distinct Ecological Niches: A Multifaceted Functional Health Perspective. Front. Microbiol. 2018, 9, 2899. [Google Scholar] [CrossRef]
- Li, T.; Liu, Z.; Zhang, X.; Chen, X.; Wang, S. Local Probiotic Lactobacillus crispatus and Lactobacillus delbrueckii Exhibit Strong Antifungal Effects Against Vulvovaginal Candidiasis in a Rat Model. Front. Microbiol. 2019, 10, 1033. [Google Scholar] [CrossRef]
- Fuochi, V.; Cardile, V.; Petronio Petronio, G.; Furneri, P.M. Biological properties and production of bacteriocins-like-inhibitory substances by Lactobacillus sp. strains from human vagina. J. Appl. Microbiol. 2019, 126, 1541–1550. [Google Scholar] [CrossRef]
- Breshears, L.M.; Edwards, V.L.; Ravel, J.; Peterson, M.L. Lactobacillus crispatus inhibits growth of Gardnerella vaginalis and Neisseria gonorrhoeae on a porcine vaginal mucosa model. BMC Microbiol. 2015, 15, 276. [Google Scholar] [CrossRef]
- Tortelli, B.A.; Lewis, W.G.; Allsworth, J.E.; Member-Meneh, N.; Foster, L.R.; Reno, H.E.; Peipert, J.F.; Fay, J.C.; Lewis, A.L. Associations between the vaginal microbiome and Candida colonization in women of reproductive age. Am. J. Obstet. Gynecol. 2020, 222, 471.e1–471.e9. [Google Scholar] [CrossRef] [PubMed]
- Cho, S.; Kim, D.; Lee, Y.; Kil, E.J.; Cho, M.J.; Byun, S.J.; Cho, W.K.; Lee, S. Probiotic Lactobacillus Paracasei Expressing a Nucleic Acid-Hydrolyzing Minibody (3D8 Scfv) Enhances Probiotic Activities in Mice Intestine as Revealed by Metagenomic Analyses. Genes 2018, 9, 276. [Google Scholar] [CrossRef] [PubMed]
- Vadala, M.; Testa, C.; Coda, L.; Angioletti, S.; Giuberti, R.; Laurino, C.; Palmieri, B. Vulvovestibular Syndrome and Vaginal Microbiome: A Simple Evaluation. J. Clin. Med. Res. 2018, 10, 688–692. [Google Scholar] [CrossRef] [PubMed]
- Takano, T.; Kudo, H.; Eguchi, S.; Matsumoto, A.; Oka, K.; Yamasaki, Y.; Takahashi, M.; Koshikawa, T.; Takemura, H.; Yamagishi, Y.; et al. Inhibitory effects of vaginal Lactobacilli on Candida albicans growth, hyphal formation, biofilm development, and epithelial cell adhesion. Front. Cell. Infect. Microbiol. 2023, 13, 1113401. [Google Scholar] [CrossRef]
- Santos, C.M.A.; Pires, M.C.V.; Leao, T.L.; Silva, A.K.S.; Miranda, L.S.; Martins, F.S.; Silva, A.M.; Nicoli, J.R. Anti-inflammatory effect of two Lactobacillus strains during infection with Gardnerella vaginalis and Candida albicans in a HeLa cell culture model. Microbiology 2018, 164, 349–358. [Google Scholar] [CrossRef]
- Navarro, S.; Abla, H.; Colmer-Hamood, J.A.; Ventolini, G.; Hamood, A.N. Under conditions closely mimicking vaginal fluid, Lactobacillus jensenii strain 62B produces a bacteriocin-like inhibitory substance that targets and eliminates Gardnerella species. Microbiology 2023, 169, 001409. [Google Scholar] [CrossRef]
- De Luca, A.; Zelante, T.; D’Angelo, C.; Zagarella, S.; Fallarino, F.; Spreca, A.; Iannitti, R.G.; Bonifazi, P.; Renauld, J.C.; Bistoni, F.; et al. IL-22 defines a novel immune pathway of antifungal resistance. Mucosal Immunol. 2010, 3, 361–373. [Google Scholar] [CrossRef]
- Liang, S.C.; Tan, X.Y.; Luxenberg, D.P.; Karim, R.; Dunussi-Joannopoulos, K.; Collins, M.; Fouser, L.A. Interleukin (IL)-22 and IL-17 are coexpressed by Th17 cells and cooperatively enhance expression of antimicrobial peptides. J. Exp. Med. 2006, 203, 2271–2279. [Google Scholar] [CrossRef]
- Tachedjian, G.; Aldunate, M.; Bradshaw, C.S.; Cone, R.A. The role of lactic acid production by probiotic Lactobacillus species in vaginal health. Res. Microbiol. 2017, 168, 782–792. [Google Scholar] [CrossRef]
- Hearps, A.C.; Tyssen, D.; Srbinovski, D.; Bayigga, L.; Diaz, D.J.D.; Aldunate, M.; Cone, R.A.; Gugasyan, R.; Anderson, D.J.; Tachedjian, G. Vaginal lactic acid elicits an anti-inflammatory response from human cervicovaginal epithelial cells and inhibits production of pro-inflammatory mediators associated with HIV acquisition. Mucosal Immunol. 2017, 10, 1480–1490. [Google Scholar] [CrossRef]

Disclaimer/Publisher’s Note: The statements, opinions and data contained in all publications are solely those of the individual author(s) and contributor(s) and not of MDPI and/or the editor(s). MDPI and/or the editor(s) disclaim responsibility for any injury to people or property resulting from any ideas, methods, instructions or products referred to in the content. |
© 2024 by the authors. Licensee MDPI, Basel, Switzerland. This article is an open access article distributed under the terms and conditions of the Creative Commons Attribution (CC BY) license (https://creativecommons.org/licenses/by/4.0/).
Share and Cite
Horng, H.-C.; Xu, J.-W.; Kuo, Y.-S.; Chen, Y.-S.; Chiu, Y.-H.; Tsui, K.-H.; Tung, Y.-T. Dual Mechanisms of Action: Anti-Candida and Anti-Inflammatory Potential of Lactobacillus Fermentation Broth in Treating Vulvovaginal Candidiasis. J. Fungi 2025, 11, 18. https://doi.org/10.3390/jof11010018
Horng H-C, Xu J-W, Kuo Y-S, Chen Y-S, Chiu Y-H, Tsui K-H, Tung Y-T. Dual Mechanisms of Action: Anti-Candida and Anti-Inflammatory Potential of Lactobacillus Fermentation Broth in Treating Vulvovaginal Candidiasis. Journal of Fungi. 2025; 11(1):18. https://doi.org/10.3390/jof11010018
Chicago/Turabian StyleHorng, Huann-Cheng, Jin-Wei Xu, Yi-Shan Kuo, Yu-Sin Chen, Yu-Hsuan Chiu, Kuan-Hao Tsui, and Yu-Tang Tung. 2025. "Dual Mechanisms of Action: Anti-Candida and Anti-Inflammatory Potential of Lactobacillus Fermentation Broth in Treating Vulvovaginal Candidiasis" Journal of Fungi 11, no. 1: 18. https://doi.org/10.3390/jof11010018
APA StyleHorng, H.-C., Xu, J.-W., Kuo, Y.-S., Chen, Y.-S., Chiu, Y.-H., Tsui, K.-H., & Tung, Y.-T. (2025). Dual Mechanisms of Action: Anti-Candida and Anti-Inflammatory Potential of Lactobacillus Fermentation Broth in Treating Vulvovaginal Candidiasis. Journal of Fungi, 11(1), 18. https://doi.org/10.3390/jof11010018

